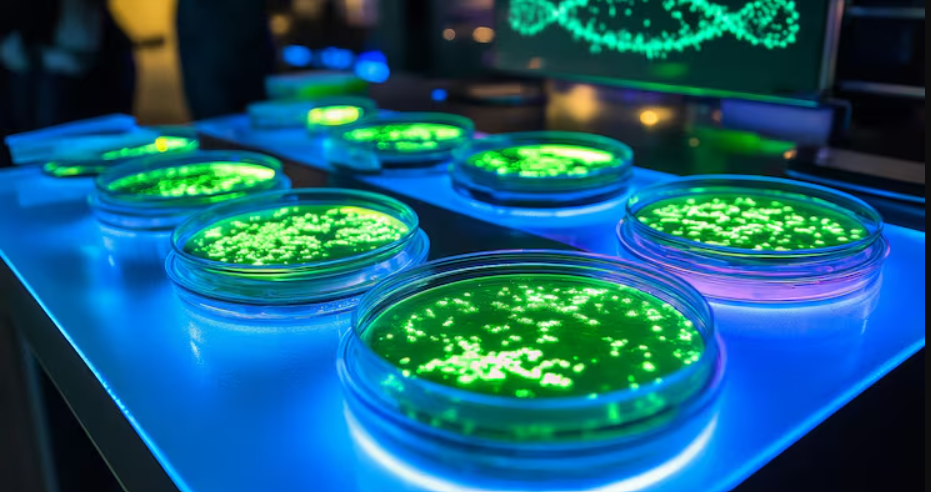
Marine and space biotechnology: Emerging frontiers for India

Marine and space biotechnology: Emerging frontiers for India
Concept
Marine biotechnology
Marine biotechnology involves studying microorganisms, algae, and other marine life to discover bioactive compounds, enzymes, biomaterials, food ingredients, and biostimulants.
Marine organisms are adapted to high pressure, high salinity, low light and nutrient-poor conditions, making them sources of novel molecules.
Space biotechnology
Space biotechnology, meanwhile, studies how microbes, plants, and human biological systems behave under microgravity and radiation
Why India needs marine and space biotechnology
Marine biotechnology
India has:
Coastline of over 11,000 km
Exclusive Economic Zone (EEZ) of over 2 million sq. km
Despite rich marine biodiversity:
India’s share in global marine outputs remains low.
Potential benefits:
New sources of food, energy, chemicals and biomaterials
Reduced pressure on land, freshwater and agriculture
Support to Blue Economy and sustainable growth
Space biotechnology
Critical for India’s long-term space exploration ambitions.
Enables:
Safe food production in space
Human health management
Biological manufacturing in extreme environments
Strategic relevance for future space stations and deep-space missions.
India’s current status
Marine biotechnology in India
Domestic production:
Seaweed cultivation remains modest at ~70,000 tonnes annually.
Import dependence:
India imports seaweed-derived products such as:
Agar
Carrageenan
Alginates
Used in food, pharmaceuticals, cosmetics, and medical applications.
Targeted initiatives under the Blue Economy agenda, the Deep Ocean Mission, and, more recently, the BioE3 are pushing the sector toward integrated marine biomanufacturing, linking cultivation, extraction, and downstream applications.
Strategic shift:
Movement towards integrated marine biomanufacturing, linking:
Cultivation
Extraction
Downstream value-added applications
Institutional and private efforts:
ICAR–Central Marine Fisheries Research Institute
Private players such as Sea6 Energy and ClimaCrew
State-level initiatives like Vibrant Gujarat Regional Conference
Trend:
Shift towards integrated marine biomanufacturing (cultivation → extraction → downstream products).
Space biotechnology in India
Led by Indian Space Research Organisation.
Microgravity biology programme studies:
Microbes
Algae
Biological systems
Focus areas:
Food production
Life-support regeneration
Human health in space
Limitation:
Private sector participation remains limited due to nascent nature of the field.
International experience
European Union
Invests heavily in:
Marine bioprospecting
Algae-based biomaterials
Bioactive compounds
Supported by shared research infrastructure such as:
European Marine Biological Resource Centre
China
Rapid expansion of:
Seaweed aquaculture
Marine bioprocessing
Strong scale advantage in marine biomass.
United States
Global leader in space biotechnology.
Research conducted through:
NASA
International Space Station
Focus areas:
Microbial behaviour
Protein crystallisation
Stem cells
Closed-loop life-support systems
Applications in:
Drug discovery
Regenerative medicine
Long-duration human missions
Key challenges
Slow and fragmented research and development.
Limited integration across:
Research institutions
Industry
Policy frameworks
Low private-sector participation, especially in space biotechnology.
Way forward
Develop a dedicated national roadmap with:
Clear timelines
Defined outcomes
Strengthen:
Integrated marine biomanufacturing ecosystems
Public–private partnerships
Translational research and scaling
Position India as a global hub for futuristic biomanufacturing.
Prelims Practice MCQs
Q. With reference to marine biomass production in India, consider the following statements:
India’s annual cultivated seaweed production is less than one lakh tonnes.
India is largely self-sufficient in seaweed-derived products such as agar and alginates.
Seaweed-derived products are used in pharmaceuticals and medical applications.
Which of the statements given above are correct?
(a) 1 and 3 only
(b) 1 and 2 only
(c) 2 and 3 only
(d) 1, 2 and 3
Answer: (a)
Explanation:
India produces ~70,000 tonnes of cultivated seaweed → Statement 1 correct.
India imports agar, carrageenan and alginates → Statement 2 incorrect.
These products are widely used in pharma and medical sectors → Statement 3 correct.
